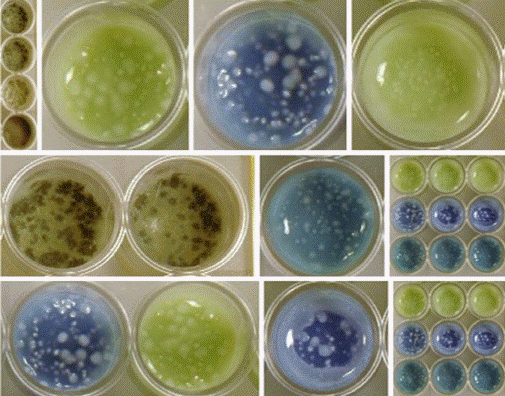
Immagine3

3° webinar della serie "I Venerdì di AITeL"
2023-06-09 16:00 - 17:15
Piattaforma Microsoft Teams
L'utilizzo dei microrganismi e dei loro metaboliti per la conservazione degli alimenti è iniziato migliaia di anni fa. I microrganismi coinvolti in queste attività appartengono a specie la cui sicurezza d’uso è fuori discussione ad eccezione di alcuni aspetti legati all’antibiotico-resistenza. Il compito di questi microrganismi è in alcuni casi duplice, ovvero essere responsabili dei processi di fermentazione che portano all’ottenimento del prodotto desiderato e allo stesso tempo svolgere una funzione protettiva del prodotto stesso dallo sviluppo di microorganismi alterativi e/o patogeni. In altri casi invece, apposite “colture di protezione” vengono usate in aggiunta alle colture starter, per svolgere “il solo ruolo di protezione” dell’alimento. La loro azione protettiva si svolge attraverso la produzione acidi organici, aldeidi, perossido di idrogeno, batteriocine, e altre molecole capaci di inibire i microorganismi patogeni associati a quel particolare prodotto e/o gli eventuali microrganismi alterativi. Nonostante sia nota l'efficacia delle “colture di protezione”, ad oggi non trovano una collocazione normativa in Italia e nei diversi paesi dell’Unione Europea.
A.i.Te.l.: la voce dei tecnici del latte in Italia
A.i.Te.l. (Associazione Italiana Tecnici del Latte) rappresenta la voce dei professionisti del settore lattiero-caseario in Italia.
Grazie all'impegno costante dei suoi associati, A.i.Te.l. si posiziona come un punto di riferimento per la ricerca, lo sviluppo e l'applicazione di tecnologie avanzate nel campo della produzione del latte e dei suoi derivati.
